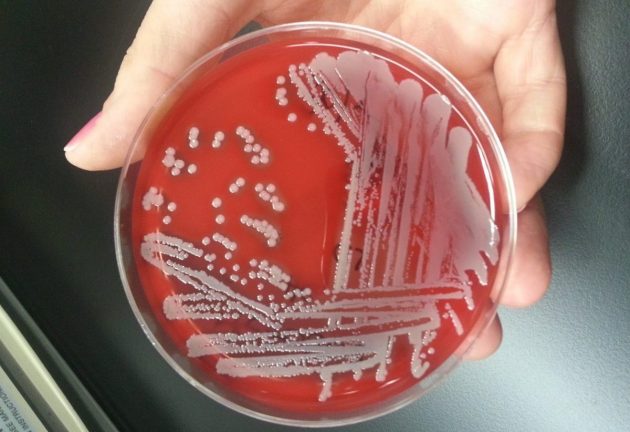

Когда на лице появляется уродство в виде болезненной отечности, говорить о профилактических мерах уже поздно. Но, зная, почему ячмень выскакивает на глазу, можно предупредить его проявление.
Некоторые люди за всю жизнь не сталкиваются с его развитием, а их могло бы быть значительно больше.
Суть заболевания
Все проблемы происходят из-за воспаления сальных желез. В их протоки попадает инфекция, которая закупоривает собой канал, начинает там зреть и постепенно выходит наружу.
Такой простой процесс на самом деле оборачивается:
- Болезненными ощущениями.
- Зудом на месте воспаления.
- Слезливостью.
- Повышением местной температуры.
- Отечностью.
- На завершающей стадии появлением гнойного образования, которое прорывает наружу (чаще ночью).
Причины появления воспалительного процесса
Есть несколько факторов, которые приводят к поражению сальных желез. От причин появления ячменя на глазу и лечение выбирается соответствующее. Поэтому так важно определить, чем именно произведено поражение:
Причиной появления ячменя на глазу чаще всего является инфекция, но в большинстве случаев это известный своими агрессивными качествами в отношении человеческого организма золотистый стафилококк. Именно его находили при проведении исследований в 90% проявления болезни.
Обычно причиной его появления в организме считают недостаточно соблюденные правила личной гигиены. Кроме немытых рук и чужих полотенец в данном случае прибавляются:
- Использование чужой декоративной косметики.
- Недостаточно точное соблюдение правил использования контактных линз.
- Работа в пыльных помещениях или продолжительное пребывание на улице при сильном ветре.
Усугубить картину могут общее ослабление организма хроническими или острыми болезнями, наличие офтальмологических заболеваний, снижающих местный иммунитет. В таких случаях заболевание может принимать особо тяжелые формы и заканчиваться рядом осложнений.
Иногда причиной заболевания становятся вирусы. Чаще это герпес и аденовирус. Клиническая картина сходна с бактериальной формой, однако лечение назначается совершенно другое. Это – еще одна причина не начинать задействовать медикаменты самостоятельно, а обратиться к специалистам.
Проблема века, которая с каждым днем становится все популярнее – аллергия. Склонность к аллергическим реакциям у населения растет, как и количество аллергенов. Одно из ее проявлений – ячмень, который образуется в результате реакции на химические вещества, пыль, косметические средства, а иногда и на материал линз ил их смазку.
Методы лечения
Вне зависимости от чего бывает ячмень на глазу, лечение его происходит приблизительно одинаково.
Если иммунитет больного достаточно сильный, даже заболев, организм активно бороться с инфекцией. В результате до стадии созревания, когда появляется гнойник и инфекция выходит наружу, дело даже не доходит. Без всякого лечения покраснение проходит за несколько дней самостоятельно, и даже особых неприятных ощущений минимальное проявление.
Впрочем, люди со слабым иммунитетом, обратившись вовремя к врачу, могут получить тот же результат. Если прийти в момент, когда проблема только в небольшом покраснении, медикаментозное лечение дает отличный эффект.
При бактериальном варианте назначаются противовоспалительные мази и капли, сухое тепло (хорошо показывает себя привычная УВЧ-терапия), если случай сложный – антибиотики.
Когда вирусы становятся причиной появления ячменя на глазу, и лечение должно быть соответственным. Антибиотики не оказывают необходимого действия. Их заменяют противовирусные препараты, местные в форме капель с интерфероном и общие, в таблетированой форме. Кроме того, проводится общее укрепление организма.
В случае, когда речь идет об аллергии, все начинается с антигистаминных препаратов. Однако при сложном течении воспалительного процесса одновременно используются антибактериальные средства, вплоть до антибиотиков.
В особо запущенном состоянии может идти речь о хирургическом вмешательстве. Самостоятельно вскрывать гнойную вершину нельзя ни в коем случае.
Категории людей, склонных к проявлению заболевания
По статистическим исследованиям медиков, около пятой части населения земного шара имеют в своем организме золотистый стафилококк, однако заболевают от этого далеко не все. Да и другие формы болезни касаются немногих.
Изучая, почему ячмень появляется на глазу, ученые пришли к выводу, что есть группы людей, которые подвержены особому риску:
- С генетической склонностью к заболеванию.
- С ослабленным иммунитетом.
- Если есть в анамнезе хронические заболевания. Особое внимание- диабетикам, людям с нарушениями органов желудочно-кишечного тракта и эндокринной системы.
- Если есть острые или хронические заболевания глаз.
- Нарушение правил гигиены и (или) контакт с больными.
- Склонность к аллергиям.
- Нарушение правил пользования контактными линзами.
Особое внимание на свое здоровье следует обратить пациентам, которые неоднократно обращались по поводу этого заболевания. Рецидивирующие формы не только опасны сами по себе, но и являются показателем сильно ослабленной иммунной системы. Первыми шагами должны быть посещение эндокринолога, иммунолога, гастроэнтеролога, терапевта и сдача анализов RW и на сахар.
Зная, от чего появляется ячмень на глазу, можно постараться избавится от проблемы до ее появления.
Здоровый способ жизни, правильное питание, выполнение элементарных правил личной гигиены – залог функционирования здорового организма. Если же хронические заболевания имеют место, не стоит отчаиваться. Многие из них излечимы, если работать с грамотными специалистами и придерживаться всех наставлений.
Другие можно контролировать, избегая рецидивов. В таком случае причин появления ячменя на глазу не будет, как и причин для беспокойства.
Кто входит в группу риска?
Непосредственной причиной появления ячменя на глазу является проникновение инфекции в железу, ее закупорка и скопление внутри воспалительного экссудата. У некоторых людей это происходит особенно легко, из-за чего они болеют ячменем намного чаще.
К группе риска относятся:
- люди с жирной кожей, их сальные железы широкие, что существенно облегчает проникновение в них патогенных микроорганизмов;
- дети и подростки — они часто заносят инфекцию в глаза, прикасаясь к ним немытыми руками;
- женщины, пользующиеся косметикой, особенно рискуют девушки, использующие чужие косметические средства;
- лица, страдающие сахарным диабетом, фурункулезом, хроническими болезнями желудочно-кишечного тракта;
- люди с гиповитаминозом, сниженным иммунитетом, хроническими воспалительными заболеваниями век (блефарит, демодекоз);
- мужчины и женщины, носящие контактные линзы — микробы могут попасть в конъюнктивальную полость вместе с линзой или плохо вымытыми руками.
Почему появляется наружный ячмень?
Причиной образования наружного ячменя на глазу является попадание инфекции в сальную или потовую железу. Это приводит к острому воспалению ее стенок, закупорке выводных проток и скоплению гноя. Веко в этом месте краснеет, опухает и становится горячим. Человек жалуется на дискомфорт и боли в глазу.
К инфекции особенно восприимчивы люди с нарушением работы иммунной системы. Причиной возникновения ячменя на глазу у них может быть попадание на веки даже небольшого количества патогенных микроорганизмов.
У лиц же с хорошим иммунитетом проникновение инфекционных агентов не всегда приводит к образованию ячменя. Их иммунная система быстро уничтожает микробы и не допускает развития воспаления.
Почему появляется внутренний ячмень?
Причиной появления внутреннего ячменя является проникновение инфекции в мейбомиевые железы, которые располагаются ближе к внутреннему краю век. Эту патологию также называют мейбомитом.
В отличие от наружного, внутренний ячмень можно увидеть только при вывороте века. В некоторых случаях мейбомит приобретает хроническое течение и в скором времени приводит к формированию халязиона. Подробнее о симптомах и лечении внутреннего ячменя?
Общие причины появления ячменя
Рассмотрим, какие причины провоцируют появления ячменя на глазу. В подавляющем большинстве случаев он возникает в результате инфицирования золотистым стафилококком. Этот вид микроорганизмов вызывает ряд гнойных заболеваний.
Некоторые из них представляют серьезную угрозу жизни человека. Stahpylococcus Aureus вызывает развитие угрей, фурункулов, абсцессов. Он нередко является возбудителем менингита, остеомиелита, эндокардита и даже сепсиса.
Согласно статистике, носителями золотистого стафилококка является около 25-40 % населения нашей планеты. У здоровых людей бактерии чаще всего обитают в носовой полости и гортани, реже – под мышками и на волосистой части головы. В норме иммунная система в состоянии противостоять микроорганизмам, не допуская развития воспалительных заболеваний.
У лиц с ослабленным иммунитетом наблюдается повышенная восприимчивость к золотистому стафилококку. Бактерия попадает в глаз и сразу же приводит к развитию воспалительного процесса.
Именно неспособность иммунной системы противостоять инфекционным агентам является причиной частых ячменей на глазах. Этим можно объяснить тот факт, что некоторые люди постоянно сталкиваются с этой проблемой, а другие ни разу в жизни не болели ячменем.
Гораздо реже возбудителем инфекции выступают грибки или демодекс – клещ, живущий на коже каждого третьего человека. Demodex вызывает появление прыщей и угрей, а у некоторых людей приводит к демодекозному блефариту. Такое воспаление краев век имеет хроническое течение и плохо поддается лечению.
Попадание инфекции на веки не всегда сопровождается формированием ячменя. Для развития болезни требуются особые условия. На сегодняшний день известен ряд провоцирующих факторов, способствующих появлению заболевания.
Нарушение правил гигиены
Естественно, несоблюдение правил личной гигиены является непосредственной причиной занесения инфекции в глаза. Если бактерии попадут в ослабленный и восприимчивый организм, воспаления не избежать.
Чаще всего к инфицированию приводит:
- использование грязных или чужих полотенец;
- привычка тереть глаза грязными руками;
- расчесывание век;
- применение дешевой, некачественной, чужой косметики;
- использование неочищенных аппликаторов и щеточек для нанесения макияжа;
- несоблюдение правил хранения и использования контактных линз;
- несвоевременное мытье рук после игр на улице у детей.
Родители зачастую не могут уследить за ребенком, из-за чего тот трет глаза немытыми руками. Микробы сразу же попадают на веки и в конъюнктивальную полость, вызывая развитие воспалительного процесса. Именно это является главной причиной образования ячменя на глазу у детей.
Переохлаждение
Распространено мнение, что именно переохлаждение приводит к появлению ячменя. Однако на самом деле все обстоит несколько иначе. Под действием холода ослабляется иммунная система, из-за чего организм становится крайне восприимчив к инфекции. Если человек является носителем золотистого стафилококка или демодекса, у него сразу же появляется ячмень.
Слабый иммунитет
Наиболее частая и явная причина возникновения ячменя на глазу – нарушение работы иммунной системы. В некоторых случаях иммунитет снижается из-за хронических заболеваний, неправильного питания, воздействия стрессовых факторов.
Причины снижения иммунитета:
- частые диеты, нерациональное питание, нехватка в рационе жизненно важных витаминов, макро- и микроэлементов;
- хронические болезни желудочно-кишечного тракта, приводящие к нарушению всасывания питательных веществ;
- постоянное переутомление, частые стрессы, затяжная депрессия, повышенная раздражительность, нерегулярный сон;
- тяжелые системные заболевания, длительное лечение антибиотиками, перенесенные травмы или операции, ВИЧ-инфекция.
Частые ячмени (равно как и фурункулы) – тревожный признак, указывающий на сбой в работе иммунной системы. Поэтому при их появлении необходимо как можно скорее обратиться к врачу. Специалист выяснит причину снижения иммунитета и назначит эффективное лечение.
Блефарит
Блефаритом называют инфекционное воспаление краев век. Заболевание обычно имеет вялое хроническое течение и плохо поддается лечению. Блефарит может быть передним или задним краевым, однако чаще всего поражается вся толща века.
Болезнь проявляется покраснением и легкой отечностью век, слезотечением. Пациенты жалуются на боли и дискомфорт в глазах, нередко наблюдается неправильный рост ресниц.
Блефариты чаще развиваются у людей с ослабленным иммунитетом, синдромом сухого глаза и некоррегированными аномалиями рефракции. Особенно подвержены болезни лица с астигматизмом и дальнозоркостью, отказывающиеся от ношения очков.
Демодекоз
Часто хронические блефариты вызывает клещ рода Demodex. Человек может болеть на протяжении многих месяцев, даже не зная об этом. Под действием провоцирующих факторов происходит активация инфекции. Клещи проникают в железы век, где и вызывают воспаление. Своевременное лечение демодекозного блефарита позволяет предупредить появление ячменя.
Заболевание развивается вследствие попадания инфекции в сальные, потовые или мейбомиевые железы. Чаще всего возбудителем выступает золотистый стафилококк или клещ рода Demodex. Появлению ячменя способствует нарушение работы иммунной системы, переохлаждение и несоблюдение правил личной гигиены. Болеют преимущественно люди с ослабленным иммунитетом, женщины, пользующиеся косметикой, и дети.
Частые ячмени могут указывать на проблемы с желудочно-кишечным трактом или сахарный диабет. Поэтому при появлении проблемы следует проконсультироваться с гастроэнтерологом и эндокринологом. Также стоит определить уровень глюкозы и гликозилированного гемоглобина в крови.
Автор: Алина Лопушняк, врач-офтальмолог, специально для Okulist.pro
Что такое ячмень на глазу
Ячмень на глазу (гордеолум) – это заболевание, которое вызвано инфицированием фолликула ресницы или прилегающей к нему сальной железы. Чаще всего болезнь появляется на одном глазу, но в некоторых случаях может поражать и оба глаза.
Бактерии, грибок или клещи, попадая в волосяную луковицу, начинают стремительно размножаться. Проток, который выпускает секрет, закупоривается, и железа начинает наполняться гнойным содержимым.
При внутреннем ячмене воспаляется мейбомиевая железа, располагающаяся в середине века у основания ресниц. В этом случае на внутренней поверхности можно увидеть покраснение с желтым пятном. При этом снаружи веко припухает, появляются отек и сильные болевые ощущения.
Почему появляется ячмень на глазу
Чаще всего причиной воспалительного процесса является бактериальная инфекция. Практически в 90% случаев главным возбудителем ячменя становится золотистый стафилококк. В результате воспалительного процесса происходит закупорка сальной железы. Если вовремя начать лечение, то от болезни можно избавиться в течение 3-4 дней.
Внешние факторы как причина возникновения ячменя
Ячмень на глазу появляется под воздействием следующих внешних факторов:
- Долгие прогулки под дождем, снегом, при сильном ветре могут спровоцировать появление ячменя;
- Ячмень может появиться после длительной прогулки в мокрой обуви;
- Провоцировать заболевание могут неблагоприятные экологические условия, такие как загазованность воздуха, смог, пыль, туман, химические вещества, попадающие в атмосферу;
- Переохлаждение организма после длительного нахождения в воде;
- Использование некачественной или просроченной косметики;
- Попадание в глаза инородных частиц (мусора, ресниц, частичек косметики, насекомых, мыла);
- Длительное нахождение под палящим солнцем;
- Постоянное зрительное напряжение;
- Косметика, которую не смывают на ночь;
- Плохо промытые или неправильно хранящиеся контактные линзы;
- Использование чужих спонжев, щеточек для нанесения туши, аппликаторов;
- Ношение контактных линз дольше положенного времени;
- Неправильный уход за контактными линзами;
- Длительное пребывание в пыльных помещениях или производственных цехах;
- Содержание большого количества неприродных ферментов, консервантов и красителей в продуктах питания;
- Бактерии стафилококка могут находиться в носу, и если человек сначала трет нос, а затем глаза, то они могут легко перемещаться, вызывая заболевание.
В группу риска входят люди с жирной кожей и наличием прыщей. При избыточной активности сальных желез создаются благоприятные условия для размножения золотистого стафилококка. Особенно часто болезнь появляется у подростков.
Женщины чаще болеют ячменем, потому как они используют косметику и больше прикасаются к глазам, чем мужчины.
Ослабленный иммунитет
Еще одной причиной от чего появляется ячмень на глазу является ослабление иммунитета, которое может произойти в следующих случаях:
- При неполноценном питании, употреблении недостаточного количества витаминов и микроэлементов;
- При дисбактериозе;
- После частых простудных заболеваний;
- При тяжелых инфекционных болезнях, вызванных вирусами или бактериями (сальмонеллезе, ротавирусе, менингите);
- При постоянных стрессах, переутомлениях;
- При сильных физических нагрузках на организм;
- При употреблении лекарственных препаратов: антибиотиков, кортикостероидов, оральных контрацептивов;
- При заболеваниях желудочно-кишечного тракта;
- Ослабление иммунитета могут спровоцировать вредные привычки, такие как курение, употребление алкоголя или наркотиков;
- При болезнях эндокринной системы;
Негативное влияние на иммунную систему оказывает недосыпание. Если в течение 2-3 недель человек спит менее 6 часов, то иммунитет падает вдвое.
Сопутствующие заболевания глаз провоцирующие появление ячменя
Ячмень может стать следствием других офтальмологических заболеваний, таких как:
- Блефарит. Это воспалительный процесс, который затрагивает края век под ресницами и возникает в результате аллергии, врожденных нарушений зрения, снижения иммунитета, гормональной перестройки организма, частых вирусных инфекций, глистных инвазий, дефицитных состояний. Через микротрещины, образующиеся в поврежденной области, инфекция проникает внутрь фолликула и сальной железы, провоцируя развитие ячменя;
- Конъюнктивит. Это воспаление слизистой оболочки глаза, возникающее в результате поражения вирусами, бактериями. Возбудителем бактериальной формы заболевания часто становится золотистый стафилококк, который также может вызвать ячмень;
- Демодекоз век. Это специфическое хроническое заболевание, обостряющееся весной и осенью, вызванное клещами вида демодекс. Они имеют микроскопические размеры и обитают в сальных железах. При этом заболевании веки зудят, краснеют, покрываются чешуйками. Часто оно провоцирует выпадение ресниц и появление ячменей. Развивается болезнь у людей с пониженным иммунитетом;
- Авитаминоз. В результате недостатка в организме ретинола возникает сухость глаз, скопление корок в уголках, ощущение «песка» в глазах. В некоторых случаях авитаминоз может стать причиной появления ячменя;
- Халязион. Под видом ячменя могут скрываться мелкие кисты и опухоли, возникающие вследствие закупорки и отека сальной железы. В острой стадии заболевания возникают такие же симптомы, как и при ячмене.
Нарушение правил личной гигиены
Часто причиной ячменя является нарушение правил личной гигиены. Для того чтобы избежать заболевания, необходимо:
- Следить за чистотой рук и ногтей. Открытые участки кожи подвергаются загрязнению. В этой грязи находится большое количество болезнетворных микробов, которые легко могут вызвать заболевание, попадая в глаза. Поэтому нужно регулярно мыть руки после посещения туалета, общественных мест и контакта с животными. Детей с раннего возраста нужно приучать не дотрагиваться до глаз грязными руками;
- Стоит регулярно мыть и обрабатывать щеточки и аппликаторы косметических средств, контактирующие с глазами. Не рекомендуется применять чужую косметику;
- Нельзя использовать чужие полотенца для рук и лица или носовые платки. Если есть необходимость, лучше воспользоваться бумажными салфетками;
- Людям, использующим контактные линзы, необходимо особое внимание уделять уходу за ними и правилам ношения;
- Если нет системы фильтрации, то для умывания лучше использовать не проточную воду, а специально подготовленную, предварительно очищенную и смягченную. Для этого ее нужно прокипятить и остудить;
- Не стоит сразу после сна тереть глаза, предварительно нужно умыться.
Заразен ли ячмень на глазу и кто чаще заболевает
Чаще всего болезнь появляется у детей, потому что они трогают глаза грязными руками, а иммунная система еще недостаточно сформировалась. Также заболеванию подвержены женщины, применяющие декоративную косметику для глаз.
На счет того, заразен ли ячмень, мнения офтальмологов разделяются. Воспаление проявляется локально и количество гноя при вскрытии ячменя слишком мизерное, для того чтобы произошло заражение.
Людям со слабым иммунитетом или другими глазными заболеваниями стоит ограничить контакт с пациентом. Не рекомендуется пользоваться одним и тем же полотенцем, косметикой или носовым платком.
После того как ячмень вскрылся, пациент может потереть глаз, при этом на руке останутся частички гноя с патогенными бактериями, поэтому в этот период лучше воздержаться от рукопожатий.
Как определить что у вас вскочил ячмень
На наличие ячменя могут указывать следующие симптомы:
- Жжение и зуд края века появляются в начальной стадии заболевания до развития основных симптомов;
- Отек, распространяющийся на одно веко или на весь глаз;
- Покраснение конъюнктивы глаза;
- В редких случаях может повышаться температура тела и увеличиваться лимфатические узлы;
- На краю пораженного века появляется небольшой плотный бугорок, на верхушке которого образуется белая или желтоватая головка;
- Примерно на 3-5-й день происходит вскрытие ячменя, при этом он прорывается и выделяются кусочки омертвевшей ткани и гноя;
- После того как гнойник вскрывается, болевые ощущения ослабевают;
- Затем отек постепенно спадает и краснота исчезает;
- Симптомы ячменя схожи с признаками халязиона, поэтому, если вскрытие не происходит и уплотнение остается, необходимо обратиться за консультацией к врачу.
Рекомендации по гигиене для профилактики заболевания
Для того чтобы предотвратить заболевание, необходимо:
- Полноценно питаться и употреблять достаточное количество витаминов;
- Соблюдать правила личной гигиены;
- Не тереть и не трогать глаза грязными руками;
- Использовать только личные полотенца и носовые платки;
- Удалять на ночь косметику с помощью специальных средств или детского мыла;
- Использовать только личную косметику, не применять чужие тени и туши;
- Не давать пользоваться своими косметическими средствами для глаз другим людям, в том числе и близким родственникам;
- Правильно ухаживать за контактными линзами, перед их надеванием обязательно мыть руки с мылом;
- Хранить линзы в специальном растворе;
- Одеваться по погоде, подбирать правильную обувь и избегать переохлаждения;
- Укреплять иммунную систему, заниматься зарядкой и регулярно гулять на свежем воздухе;
- Своевременно лечить любые офтальмологические заболевания;
При появлении симптомов ячменя необходимо обратиться за консультацией к офтальмологу.
Ячмень на глазу – острое гнойное воспаление желез века, которое может распространиться и на окружающую соединительную ткань. Появление ячменя связано с развитием бактериальной инфекции, что часто возникает на фоне сниженного иммунитета. Избавиться от назойливого заболевания и повысить иммунитет помогут лекарства от ячменя.
Ячмень начинается с легкого зуда края века, затем на этом месте появляется небольшая припухлость. Пальпация припухлости болезненна, а через несколько дней на верхушке припухлости формируется желтая головка. При ее вскрытии выделяется гной, после чего постепенно наступает выздоровление. Ячмень может быть наружным и внутренним. При наружном воспаляется волосяной фолликул ресницы или сальная железа. При внутреннем ячмене происходит воспаление мейбомиевых желез – видоизмененных сальных желез, расположенных в толще века.
Почему появляется
Ячмень на глазу возникает в результате острого гнойного воспаления сальной железы на веке или волосяной луковице ресницы. Термин «внешний ячмень на глазу» используется при закупорке луковицы ресницы. А понятие «внутренний ячмень на глазу» применяется при воспалении сальной железы века, так называемой мейбоевой железы.
Причиной этого воспалительного процесса чаще всего служит стафилококк. Распространение инфекции провоцирует ослабление иммунитета при простудных и хронических заболеваниях, на фоне которых и развивается ячмень в глазу.
Классификация
- Наружный ячмень является результатом инфицирования или закупорки фолликула ресниц и прилежащих желез Цейса или Моля. Он часто возникает в сочетании с блефаритом. Симптомы включают боль, покраснение и болезненность края века, иногда со слезотечением, светобоязнью и ощущением инородного тела. При «созревании» появляется небольшое желтоватое пятно в основании ресниц, указывающее на нагноение, окруженное покраснением, уплотнением и диффузным отеком. Через 2-4 дня очаг вскрывается с выделением гноя и ослаблением боли.
- Внутренний ячмень, который встречается значительно реже, является результатом инфицирования мейбомиевой железы. Симптомы те же, что и у халазиона, с болью, покраснением и отеком задней поверхности конъюнктивы хряща. Осмотр тарзальной конъюнктивы выявляет небольшое возвышение или участок желтого цвета в месте пораженной железы. Позднее формируется абсцесс, созревая на конъюнктивальной стороне века; иногда он прорывается через кожу. Спонтанный разрыв происходит редко, и часто отмечается рецидив.
Часто ячмени развиваются у ослабленных и анемичных людей, с пониженной сопротивляемостью организма.
Иногда ячмени рецидивируют, что обычно сочетается с общим фурункулезом, особенно при сахарном диабете. При этом большое значение имеет нарушение физиологической активности кишечного тракта, обусловленное привычными запорами.
Причины
Основная причина возникновения ячменя на глазу — воспалительный процесс. Провоцирует его при этом бактериальная инфекция, попавшая каким-то образом в организм или просто активировавшаяся там. Чаще всего это золотистый стафилококк, который большую часть жизни человека преспокойно дремлет в организме, если его не трогать.
Согласно статистике, 20% людей являются его потенциальными носителями на протяжении всей своей жизни, совершенно не подозревая об этом. Если его не будить, он может остаться бездейственным, не нанеся абсолютно никакого вреда человеку. Активировать его могут самые разные факторы: несоблюдение элементарных правил гигиены, неосторожное переохлаждение организма, ослабленный после болезни иммунитет, глазные заболевания — блефарит, демодекоз.
Именно эти причины объясняют, почему начинает нарывать на веке (на нижнем или верхнем) гнойник, доставляющий очень неприятные ощущения за 5–6 дней своего полного вызревания. Эти обстоятельства провоцируют изначально развитие бактериальной инфекции, затем — воспалительного процесса и, наконец, непосредственно самого заболевания.
Нарушение правил гигиены
Нежная, тонкая слизистая оболочка глаза — субстанция, очень чувствительная к бактериям и микробам. Как только грязь ее касается, она раздражается. Во влажной среде любое загрязнение находит благодатную почву, чтобы начать воспалительную реакцию и последующее нагноение органов зрения. Попадание в глаза различных инородных частичек, пыли, грязи, недостаточный или неправильный уход — все это провоцирует развитие заболевания.
Чтобы понять, какие причины появления ячменя на любом веке (на верхнем и нижнем с равным успехом) имеют место быть в вашем случае, проанализируйте досконально свой уход за глазами. К этому неприятному явлению могут привести:
- некачественная, дешевая, просроченная косметика: гель для кожи вокруг глаз, тушь для ресниц, карандаш или тени для век, подводка и др. (поэтому чаще всего ячмень появляется на верхнем веке, так как оно более подвержено влиянию этих химических веществ);
- не вымытые после улицы или туалета руки, которыми вы касаетесь глаз (трете их, подкрашиваете, вставляете линзы);
- инородные частицы в глазу (выпавшая ресничка, соринка, непромытые остатки косметических средств, мыло и пр.);
- косметика (тушь, тени, подводка), оставленная на ночь на веках;
- проблемы с контактными линзами: недостаточно промытые, давно или плохо чищенные, просроченные, слишком длительное их ношение.
Если хоть одна причина регулярно присутствует в вашей жизни, становится понятным, почему у вас время от времени появляется ячмень на глазу: из-за несоблюдения элементарных правил гигиены. Постарайтесь устранить эти нежелательные факторы — только в этом случае о заболевании можно будет забыть навсегда. Однако загрязнения — далеко не единственная причина появления ячменя на глазу.
Переохлаждение
Нередко гнойник на глазу образуется из-за переохлаждения организма, после того, как человек длительное время пробыл под холодным дождем, на морозе, в ледяной воде, ходил с мокрыми или влажными ногами и т. д. Защитные функции иммунитета снижаются под действием низких температур, в результате чего не всегда дело заканчивается простудой или гриппом. Это может послужить началом воспалительного процесса и появлению ячменя на глазу. Чаще всего это происходит из-за небрежного отношения к собственному здоровью. В данном случае причинами заболевания могут стать:
- слабый иммунитет, который нужно постоянно укреплять занятиями спортом и правильным питанием;
- любовь одеваться слишком легко, не по погоде;
- дань моде, когда зимой вместо шубы надевают ветровку на рыбьем меху и демисезонные сапожки;
- отсутствие головного убора;
- обувь плохого качества, которая постоянно промокает;
- длительные прогулки на ветру, под дождем, на морозе;
- купания в холодной (ледяной) воде без предварительного закаливания.
В жизни может случиться всякое. Иногда человек, тщательно заботящийся о своем здоровье и регулярно укрепляющий иммунитет, может в силу обстоятельств быть подвержен влиянию низких температур. Если это случилось, заболевания можно избежать, если сразу после переохлаждения выпить чашку горячего чая с медом или малиновым вареньем, надеть шерстяные носки на голые ноги, положить в них сухие горчичники, укутаться в плед.
Все эти вовремя проделанные мероприятия спасут организм от воспалительного процесса, а значит — от появления ячменя на глазу. Теперь вы знаете, почему это заболевание настигает чаще всего в холодное время года: причина — в низких температурах, вызывающих переохлаждение организма. Если свое здоровье подвергать подобным стрессам слишком часто, может дать сбой вся иммунная система, что также может спровоцировать образование гнойника на веке.
Ячмень на глазу что делать? Во первых, четко запомнить, что ни в коем случае нельзя выдавливать гной! Это не обычный прыщ. Выдавив ячмень, вы рискуете разнести болезнетворные бактерии на другие оболочки глаза
Слабый иммунитет
Когда защитные функции организма дают сбой, золотистый стафилококк (основная причина появления глазного ячменя) моментально активируется. Чтобы предотвратить образование гнойника на веке, нужно знать, какие обстоятельства могут привести к ослаблению иммунитета, стараться не допускать их в свою жизнь. К ним относятся:
- слабое здоровье по наследству, когда всевозможные вирусы регулярно цепляются к организму;
- плохое (некачественное, бедное) питание;
- различные внутренние заболевания (причина ячменя на глазу может крыться как в тяжелых хронических патологиях, так и в обычном кариесе);
- дисбактериоз (проявляет себя из-за нарушения микрофлоры кишечника, недостатка кровяных телец);
- вредные привычки;
- длительный прием лекарственных препаратов (чаще всего причина ослабленного иммунитета — антибиотики, гормональные противозачаточные средства);
- плохие экологические условия: загазованность, задымленность, выброс в атмосферу большого количества химических вредных веществ;
- регулярные стрессы, переутомление, непомерные физические и умственные нагрузки, недосыпание, плохое настроение.
Как только причина ослабленного иммунитета, из-за которой появляется ячмень под глазом, выяснена, нужно предпринять все меры, чтобы устранить ее, тем самым ускорив желанное выздоровление. При этом приходится пересматривать рацион питания (увеличивать количество потребляемых свежих фруктов, овощей, ягод, соков, мяса, рыбы), режим дня (спать не менее 8-ми часов в сутки, питаться по расписанию), освободиться от пагубного влияния вредных привычек, пролечить основные заболевания, стараться меньше переживать, избегать стрессов, не допускать черных мыслей. Именно от этих, кажущихся незначительными на первый взгляд факторов зависит иммунитет, ослабление которого — основная причина возникновения гнойного ячменя на глазу.
Первые признаки
Признаки ячменя на глазу на ранних стадиях болезни слабо выражены, поэтому их можно либо не заметить вообще, либо принять за обычный косметический дефект в виде небольшой припухлости века. Их нужно обязательно знать «в лицо», чтобы вовремя различить опасность. К самым первым вестникам ячменя на глазу относятся:
- отек века (поражено может быть как верхнее, так и нижнее);
- зуд;
- жжение;
- напряжение, чувство тяжести в веке, словно оно медленно наливается свинцом;
- хемоз, т. е. заметное покраснение века, который вскоре распространяется на всю конъюнктиву (тонкую прозрачную ткань, покрывающую глаз снаружи);
- припухлость на краю одного из век, которая носит локальный, ограниченный характер, т. е. не расползается дальше, а остается в виде маленького, твердого на ощупь бугорка;
- если надавить на новообразование, оно будет пружинить, обнаружив эластическую, достаточно плотную консистенцию;
- кожа вокруг ячменя на глазу будет воспалена, на этом месте будут болезненные ощущения;
- глаз уже на начальном этапе болезни отекает, что существенно ограничивает видимость.
При остальных же глазных заболеваниях поражается обычно край по росту ресничек, и отек распространяется на слишком обширную территорию века. Помимо вышеперечисленных симптомов не лишним будет знать первые признаки мейбомита — внутреннего ячменя на глазу, который также лучше распознать на начальном этапе заболевания.
К ним относятся все те же симптомы, что и при обычном ячмене, но только нарыв начинает зреть с внутренней стороны любого (верхнего или нижнего) века. Это доставляет гораздо больше дискомфорта и неприятных ощущений, так как гнойник будет касаться непосредственно самой конъюнктивы. Тем важнее обнаружить его сразу и вовремя начать курс лечения, что сократит течение болезни на 1–2 дня. В последующие дни признаки ячменя на глазу можно будет условно разделить на внутренние и внешние.
Симптомы
Симптомы ячменя на глазу — на крае века ощущается болезненная точка. Потом соответственно болезненной точке развивается ограниченная красноватая плотная припухлость, очень болезненная. Отек века иногда бывает таким сильным, что веки не открываются. Интенсивность боли обычно соответствует степени выраженности отека. Через 2-3 дня на краю века в воспалительном фокусе появляется гнойная точка, образуется гнойная пустула (головка).
Боль прекращается. На 3-4-й день развития ячменя пустула вскрывается, и из нее выходит гнойное содержимое с кусочками некротизированной ткани. После самопроизвольного вскрытия к концу недели симптомы (отек, гиперемия) быстро исчезают. На месте вскрытия пустулы может образоваться нежный рубчик.
Иногда одновременно могут возникнуть несколько ячменей, иногда они сливаются в один, абсцедируют. Это состояние сопровождается повышением температуры тела, головной болью, припуханием предушных и подчелюстных лимфоузлов, ухудшается общее самочувствие. В связи с особенностью кровоснабжения век (обильная венозная сеть, отток венозной крови в вены лица и вены орбиты, отсутствие клапанов в венах орбиты) ячмень века может осложняться флегмоной глазницы, тромбофлебитом орбитальных вен, тромбозом кавернозного синуса, менингитом и сепсисом. Эти опасные осложнения чаще развиваются посте попыток выдавливания гноя из абсцедирующего ячменя.
Ячмень дифференцируют с халазионом (при пальпации плотный) и дакриоаденитом (другая локализация очага воспаления).
Профилактика
В чем может заключаться профилактика ячменя на глазу? Ответ прост – в устранении всех причин, которые могут его спровоцировать. Очень часто ячмень появляется на глазах у детей. Поэтому важно, чтобы родители приучали их пользоваться только своим личным полотенцем, не прикасаться к глазам руками, даже вымытыми и даже их тыльной стороной, которую многие ошибочно считают более чистой.
Ребенок, с малых лет привыкший принимать за норму выполнение правил личной гигиены, в течение всей жизни будет защищен от многих болезней, в том числе и от ячменя. Девочка, подрастая и начиная пользоваться косметикой, должна знать, что пользоваться чужой косметикой нельзя — это может привести к инфицированию кожи, глаз. Также нужно рассказать ей о необходимости регулярно мыть щеточки, кисточки, аппликаторы, и о том, что макияж с глаз перед сном необходимо тщательно удалять. Косметика должна быть качественной.
Если у человека проблемы со зрением, и он выбрал в качестве помощников контактные линзы, нужно обязательно придерживаться правил их ношения и хранения. Регулярный прием поливитаминов, правильное сбалансированное питание помогут предотвратить появление на глазах ячменя.
Консультация хорошего иммунолога поможет избавиться от частых простудных заболеваний и предупредить рецидив ячменя. Поддержание нормального функционирования желудочно-кишечного тракта, своевременное лечение его заболеваний также является одним из средств профилактики ячменей.
Выявление и уничтожение глистов, удерживание уровня сахара в пределах допустимой нормы при сахарном диабете — все эти мероприятия сдерживают процессы развития ячменя.
Необходимо почаще бывать на свежем воздухе, особенно тем людям, которые трудятся в пыльных помещениях. При попадании соринки в глаз, ее необходимо удалить, а глаз промыть альбуцидом или отваром зверобоя, ромашки, хотя бы крепким чаем — чтобы избежать инфицирования. Переохлаждений, длительного пребывания на сильном ветру следует избегать.
Осложнения
Ускорять процесс вскрытия ячменя самостоятельным выдавливанием не рекомендуется, так как это рассеивает инфекцию в слизистую оболочку глаза, века, орбиты и приводит к таким осложнениям как мейбомит, флегмона орбиты. Так же инфекция может попасть в кровь (сепсис) и распространится по кровеносным сосудам в оболочки головного мозга (менингит).
Одним из частых осложнений ячменя является мейбомит. Мейбомит — это воспаление железы хряща века. Воспаление всегда гнойное. Хрящ века представляет собой выпуклую пластинку, которая и формирует форму века. В хряще века есть мейбомиевые железы. Эти железы являются видоизмененными сальными железами. Инфекция попадает в выводные протоки мейбомиевой железы и возникает воспаление этих желез — мейбомит.
Заболевание может быть как острым, так и хроническим. Клиника острого мейбомита схожа с клиникой ячменя ( болезненность, покраснение, отечность века), только инфильтрат расположен в толще хряща и виден на слизистой оболочке века при выворачивании века. Вскрывается воспалительный инфильтрат через слизистую оболочку.
Хронический мейбомит протекает по другому:
- по краю века отмечается покраснение, утолщение;
- желтовато — коричневатые корочки возникают из-за усиленной работы мейбомиевой железы.
Инфекция с сальным отделяемым мейбомиевой железы попадает в слизистую оболочку глаза вызывает хроническое воспаление – хронический конъюнктивит.
Лечение острого мейбомита такое же, как и лечение ячменя. Хронический мейбомит лечится антибиотиками, которые подбираются после бактериального посева с глаза.
Профилактика мейбомита заключается в периодическом выдавливании (хотя бы 2 раза в год ) сального содержимого мейбомиевых желез путем массажа век. Эту процедуру делает глазной врач или специально обученная медсестра, используя стеклянную палочку. Курс — 10 раз.
При часто появляющихся ячменях необходимо общее обследование у терапевта и обращение к врачу-иммунологу для назначения общеукрепляющего лечения (витаминотерапия, аутогемотерапия).
Вопросы и ответы
Вопрос: Здравствуйте. У моей дочери (8 лет) года два назад на глазу с внешней стороны сверху был ячмень. Мы обратились к врачу, который нам назначил прогревание, советовал также греть глаз и в домашних условиях. В итоге ячмень вырос огромный и никак не хотел прорывать. Все кончилось тем, что мы в отделении его разрезали, потом еще какое-то время заживало и спустя только пол года ушло совсем. Сейчас на том же месте опять начинает краснеть и немного подпухать. Может есть какое-то средство, чтобы остановить этот процесс в зачаточном состоянии и не доводить все опять до отделения и хирургического вмешательства. Заранее благодарна за ответ.
Ответ: Здравствуйте! Да,конечно, можно закапывать лекарственные средства в глаз антибактериальные , противовоспалительные, внутрь витамины. Более подробное лечение Вам расскажет окулист при очной консультации.
Вопрос: У меня на глазу вскочил ячмень. С чем это может быть связано и как лечить ячмень? Обязательно ли идти к врачу или можно справиться самому?
Ответ: Если ячмень созрел, тепловые процедуры противопоказаны – они только усилят гнойное воспаление. Если нет температуры – попробуйте лечение ячменя на глазу антибактериальными мазями местно, положив их под веко. При повышенной температуре без применения антибиотиков и сульфаниламидных препаратов внутрь не обойтись. Из процедур полезно УВЧ-терапия (но ее можно проводить, только если нет температуры). При запущенном процессе показана операция.
Вопрос: Здравствуйте, у меня на обоих глазах с завидной периодичностью вот уже в течение 2 месяцев вылазит так называемый ячмень. Глаза болят и опухают. Раньше помогал сульфацил натрия, теперь 2-3 дня глаз опухает, затем опухоль спадает. Через неделю снова повторяется. Ношу линзы, сначала думала, что из-за них, сменила, но проблема не ушла. как это лечить?
Ответ: Здравствуйте! Как я понимаю, речь идет о рецидивирующем ячмене. Это может быть вызвано различными состояниями организма: снижением иммунитета (в т.ч. авитаминозами), состоянием век, общими заболеваниями (эндокринные нарушения, хронические заболевания ЖКТ). Линзы тут не причем. Поэтому рекомендовано проводить стандартное лечение (антибактериальные и противовоспалительные капли и мази), а так же устранять перечисленные выше нарушения в организме.
Вопрос: Подскажите пожалуйста, чем обработать ячмень на нижнем веке — в течении 2 дней уже созрел, но никак не прорвется, глаз красный, в больницу не очень хочется, ребенку 7 лет, 1.5 месяца назад лежали с чирием в носу, вскрывали, и она ни в какую в больницу не хочет, подскажите как в домашних условиях помочь???? Закладывала мазь тетрациклиновую и капли альбуцид.
Ответ: Здравствуйте! Выбранное вами лечение антибактериальное лечение можно продолжать. Для скорейшего вскрытия гнойной головки можно применять сухое тепло, после чего в течение 7-10 дней продолжать закапывание антибактериальных препаратов.
Вопрос: Здравствуйте! Уважаемый доктор, вот уже 2-3 месяца как у меня на глазе вышел ячмень, сперва он болел и чесался, я мазала мазь «тетрациклин» вроде после этого боль и чесания прошла, но не большая опухоль осталась. Вроде как внутри что-то есть, но белой точки нет, красная. Что мне делать? Очень боюсь. Пожалуйста помогите! Жду Вашего ответа. Спасибо!
Ответ: Здравствуйте, для этого вам следует посетить окулиста. Скорее всего произошло закрытие основного протока, поэтому воспаление находится внутри. Иногда требуется сделать небольшой разрез, чтобы вылечить до конца. А иногда просто назначают антибиотики. Это очень серьезно, так что не тяните с посещением врача.
Вопрос: Здравствуйте, подскажите пожалуйста, что делать: недели 3 назад выскочил ячмень, вышел гной. Буквально через 2 дня выскочил еще один — прошла, гной вышел. А буквально на следущий день стал появляться еще один. Подскажите что делать? Спасибо.
Ответ: Здравствуйте. Рецидивирующие ячмени возникают при снижении иммунитета, повышении глюкозы в крови. Обследуйтесь по поводу сахара крови, обратитесь к офтальмологу, доктор назначит растительные препараты, повышающие иммунитет,возможно,аутогемотерапию. Обратите внимание на Ваш рацион. Исключите все сладкое и мучное, предпочтение овощам, мясу,обязательно черный хлеб. Желаю выздоровления!
Вопрос: Я часто страдаю от ячменей, подскажите современные средства борьбы с ними и можно ли от них избавиться навсегда
Ответ: Перевязка красными нитками, кукиши и промывание заваркой, впрочем, как и другие методы народной медицины, в данном случае не помогут. Более того, затягивая с визитом к врачу, вы рискуете дотянуть до сильного воспаления. Ячмень (инфицирование мейболиевой железы, выходной канал которой находится на слизистом крае века) провоцируется в результате переохлаждения организма. Поэтому, чтобы не заболеть, не переохлаждайтесь и следите за состоянием вашего иммунитета. Если Вы уже заболели, рекомендую, как можно раньше посетить офтальмолога, так как неправильное и несвоевременное лечение неизбежно приводит к осложнениям (распространению инфекции, рубцовой деформации век и дальнейшим рецидивам). Вам пропишут препараты, способные в сжатые сроки побороть инфекцию. Во время болезни лучше не забывать о личной гигиене и вытирать лицо индивидуальным полотенцем, чтобы не заразить домочадцев. Пропейте курс витаминов, не переохлаждайтесь (особенно летом под кондиционерами), займитесь иммунитетом, а также посетите терапевта.
Вопрос: Добрый день! У жены выскочил ячмень, головки не видно, около глаза небольшая опухоль, немного гноя уже вышло. Обратились в поликлинику — доктор прописал цилоксан (тобрекс) и тобрадекс. Но дело в том, что жена — кормящая мама (малышке 3 мес), а в инструкциях к тобрексу и тобрадексу написано, что кормление на время применения лучше прекратить (а мы этого не хотим, грудное молочко — лучшая еда для малыша). О цилоксане написано, что противопоказаний нет, но надо быть осторожным, т.к. есть вероятность попадания в молоко. Подскажите, пожалуйста, какие лекарства лучше применить?
Ответ: Здравствуйте! Наиболее частый возбудитель этой хвори – стафилококк, но очень желательно знать наверняка. В случае, если это таки золотистый стафилококк, тут желателен особый подход, обсудите это с врачом. Антибиотики в этом случае должны назначаться в последнюю очередь, нужно рассмотреть вариант лечения антистафилококковым бактериофагом, стафилококковым анатоксином. Всего доброго!
Вопрос: Здравствуйте! У меня 2 дня назад начал болеть правый глаз, на следующий день я заметил, что глаз чуть распух, подняв веко я увидел ячмень. Подскажите как его вылечить и сколько дней он лечиться?
Ответ: Здравствуйте! Следует посетить офтальмолога. Наиболее частый возбудитель этой хвори – стафилококк, но очень желательно знать наверняка. В случае, если это таки золотистый стафилококк, тут желателен особый подход, обсудите это с врачом. Антибиотики в этом случае должны назначаться в последнюю очередь, нужно рассмотреть вариант лечения антистафилококковым бактериофагом, стафилококковым анатоксином.
Вопрос: Здравствуйте!!! Ячмень вышел на верхнем веке внутри, особо не болит, но и проходить не проходит, уже 4 день. Не разу подобного не было. Что делать? Чувствую, что там уже появилась головка, хоть и не большая.
Ответ: Добрый день. Сейчас у Вас уже не ячмень, а халязион. Острая фаза воспаления прошла. В данном случае я бы рекомендовал инъекцию кеналога в халязион. 2-3 дня и все пройдет, если нет, то через 10 дней инъекцию можно повторить. При отсутствии эффекта халязион убирают оперативно.
Вопрос: У меня вскочил ячмень на глазу. Долго назревал и все-таки вырос. Прописали тетрациклиновую мазь. Грею разогретой солью. Но не то, чтобы все это помогало, а как–то наоборот – веко стало огромных размеров. А сегодня утром заметил, что появился второй ячмень.
Ответ: советую вам исключить сладкое, жирное и кислое. А также алкоголь, хлеб и мясо. Внутрь принимать чай из толокнянки. Кушать только отварной рис и без соли, можно с куркумой. Следите за диетой, потому как проблема на глазу – признак излишнего перевозбуждения, и возможно это печень.
Вопрос: Месяц назад у ребёнка соскочил ячмень на глазу, врач назначил нам тетрациклиновую мазь и капли глазные — левомицетин, пролечили, выздоровели. Спустя месяц опять на том же глазе воспалился ячмень, обращаться к врачу не стала, а начала лечить тем же методом, что и прежде. Скажите пожалуйста, правильно ли я поступаю и что делать, чтобы не повторилось воспаление глаза ячменем? Заранее благодарна.
Ответ: Не правильно. Если есть рецидив, то вас лечили не правильно и вы это повторяете. Нужно дообследоваться у окулиста и у педиатра. Попробовать можно глазную гидрокортизоновую мазь 1% на веки и дать ребенку попить отвар пижмы — дозы в зависимости от возраста — щепотка на кончике ножа (от года) или 1ч.л. на 200 мл кипятка (на 5 лет).
Вопрос: Здравствуйте! Скажите, ячмень на глазу как-то влияет на кормление грудным молоком? Чем лечить его кормящей маме? Можно ли кормить ребенка при наличии ячменя?
Ответ: Никак. Кормить можно лечить как обычно.
Вопрос: Как лечить ячмень на глазу?
Ответ: Пойти к врачу (а он уже припишет какие-то мази или антибиотики). Но важно помнить, что нельзя самостоятельно механически удалять, поскольку это может привести к некоторым осложнениям. Можно протирать спиртом (не менее 70% ). А чтобы недопустить этого, нужно укреплять свой имунитет (витамины). Соблюдать правила гигиены.
Вопрос: Ребенку 3 года, на глазу ячмень, температуры нет, на боли не жалуется. Назначили: сумамед суспензия, нурофен, финестил,линекс, эритромициновая мазь, виферон, ликопид. Оправдано ли такое количество препаратов и особенно антибиотика (сумамед ) ?
Ответ: В том случае, если процесс имеет распространенный характер гнойная полость больших размеров назначение антибиотиков оправданно. В данном случае, данный вопрос адекватно решить может лишь врач офтальмолог после проведения личного осмотра. Антибиотик назначает с целью предотвращения развития осложнений таких как абсцесс века, гнойный менингит. Рекомендуется спустя 3 дня проведения лечения повторно проконсультироваться с врачом офтальмологом для оценки состояния глаза и при необходимости проведения корректировки лечения ячменя на глазу.
Почему могут часто появляться ячмени на глазах?
Долгое время считалось, что ячмень на глазу появляется, если глаз «просквозило», но в настоящее время выделяется множество причин появления этой патологии. Некоторые случаи поражения глаз ячменем являются довольно уникальными, так как у определенной категории людей могут появляться сразу по 2-3 ячменя на одном глазу, при этом даже если один очаг воспаления спадает, на его месте развивается новый. В таких случаях даже эритромицин и тетрациклиновая мазь не всегда способны дать долговременный эффект. При частом появлении ячменя под глазом очень важно сразу разобраться в причинах подобного явления.
В первую очередь нужно отметить, что наиболее часто появление ячменя на глазу наблюдается весной, причем у людей, занимающихся активным спортом, риск появления подобных воспалительных процессов на веке значительно выше. Все дело в том, что весной погода крайне обманчива, и если сначала может показаться, что на улице установилась теплая погода, то уже через пару часов может значительно похолодать. Люди, занимающиеся спортом в спортзале, или те, кто делает пробежки, рискуют простудить глаз, так как после активной физической деятельности наблюдается повышенное потоотделение, сопровождающееся открытием сальных желез. Переохлаждение век может привести к снижению местного иммунитета и активизации патогенной микрофлоры.
Наиболее часто к развитию воспалительного процесса приводит золотистый стафилококк, но при определенных условиях к образованию гнойного абсцесса на глазу могут привести любые патогенные и условно-патогенные микроорганизмы.
Острым течением отличаются ячмени, которые вызываются синегнойной палочкой. В этом случае лечение должно быть комплексным, чтобы инфекция не перекинулась на оболочку глаза, так как подобное развитие болезни может привести к потере или ухудшению зрения. При поражении века синегнойной палочкой, чтобы устранить область воспаления, ее нужно прижечь лазером или спиртом, так как эритромицин не способен полностью убрать патогенную микрофлору. Кроме того, в весенний период у всех людей наблюдается авитаминоз в той или иной степени, что также способствует снижению иммунитета и образованию ячменей.
Однако, как показывает практика, появление ячменей на глазу может наблюдаться в любое время года, причем у некоторых людей даже чаще, чем у других. Все дело в том, что существует масса факторов, которые могут быть предрасполагающими к появлению ячменя:
- Заболевания ЖКТ.
- Сильное переохлаждение.
- Наличие глистных паразитов.
- Сахарный диабет.
- Нарушения в работе иммунитета.
- Нарушение обмена веществ.
Ячмень чаще развивается у женщин, чем у мужчин, и тому есть объективные причины. Как правило, у женщин чаще имеет место нарушение гигиены глаз, так как представительницы прекрасного пола касаются век во время наложения макияжа, что увеличивает риск занесения инфекции. Развитие ячменя нередко наблюдается у женщин, страдающих хроническим конъюнктивитом, поэтому при этом заболевании врачи нередко назначают эритромицин в качестве профилактической меры, направленной не недопущение воспаления век.
Симптомы ячменя на глазах
Ячмень — это гнойный фурункул, который формируется в несколько этапов. Гнойный очаг воспаления берет свое начало с появления незначительной области покраснения в области ресницы. У большинства людей, у которых ячмень возникает нечасто, подобное воспаление может протекать крайне болезненно. У людей, часто страдающих от ячменей, болезненные ощущения на начальном этапе образования воспаления века могут отсутствовать.
На протяжении следующих 2-3 дней на месте образования ячменя наблюдается лишь припухлость, но при этом стержень гнойника почти незаметен. Далее на 4-5 день образуется желтый стержень гнойника, после чего гнойник лопается и его содержимое выходит наружу. После этого ячмень постепенно проходит. Можно выделить ряд симптомов, характерных для развития ячменя:
- Покраснение кожи века в области развития гнойника.
- Отек века.
- Ощущение инородного тела в глазу.
- Слезотечение.
- Чувство жжения.
- Сухость глаза, если ячмень появился на верхнем веке.
- Сильный зуд.
- Болезненные ощущения.
- Гнойные выделения из фурункула.
В редких случаях развитие фурункула может сопровождаться повышением температуры тела и головными болями. При возникновении фурункула в области наружного или внутреннего угла глаза могут развиваться сильные отеки, распространяющиеся не только на веко, но и на область щеки и носа.
Сформировавшийся ячмень имеет сверху белое пятнышко, которое прорывается, после чего гной начинает выходить наружу. В редких случаях ячмень может исчезнуть без прорыва гнойника. Ни в коем случае не стоит самостоятельно выдавливать гнойник, так как это может привести к заражению слизистой глаза. Для проведения процедуры удаления гноя лучше всего обратиться к врачу.
Медикаментозные препараты для лечения ячменя на глазу
При частом появлении ячменя на глазу нужно в первую очередь определить, что стало причиной снижения иммунитета, ведь именно это приводит к появлению фурункулов. Средства и методы лечения ячменя довольно разнообразны, но для того чтобы фурункул исчез быстро и снова не появился, нужен комплексный подход, так как такие препараты, как эритромицин и тетрациклиновая мазь, могут дать лишь кратковременный эффект, в случае если имеется системное заболевание.
При частых ячменях следует посетить врача, который назначит проведение общего анализа крови и сдачу мазка с пораженной области. Для устранения самого фурункула и патогенной микрофлоры могут быть назначены такие лекарства, как эритромицин или тетрациклиновая мазь. Для эффективного лечения фурункулов больному очень важно придерживаться предписаний врача, особенно тех, что касаются гигиены глаза, так как именно неправильная гигиена, при наличии очага воспаления на веке, является предрасполагающим фактором для появления еще нескольких таких же фурункулов. В ходе лечения ячменя следует отказаться от использования косметики для глаз и ношения контактных линз.
При раннем обращении за медицинской помощью может быть сразу же назначен эритромицин, который способен остановить развитие гнойного абсцесса, но, как правило, такое положительное воздействие наблюдается, только если эритромицин был использован в первые часы после появления области покраснения.
Нередко для быстрого лечения ячменя требуется удаление гноя. В этом случае процедуру должен проводить врач-офтальмолог. Как правило, врач с помощью пинцета устраняет стержень гнойника и аккуратно выдавливает из полости абсцесса гной. Гной аккуратно удаляется с помощью ваты, чтобы не допустить его попадания на слизистую глаза. После удаления гноя врач может прижечь ячмень спиртом.
После устранения гнойного очага больной должен использовать эритромицин еще на протяжении нескольких дней, чтобы полностью устранить болезнетворные бактерии. Применение таких препаратов, как эритромицин и тетрациклиновая мазь, вполне способно справиться с инфекцией, ставшей причиной образования гнойника, но все же ни эритромицин, ни другие местные препараты не способны полностью устранить основную проблему, то есть нарушение обмена веществ или снижение иммунитета организма.
Меры комплексного лечения ячменя у людей, часто страдающих этим заболеванием, предполагают в первую очередь изменение образа жизни. Занятия спортом, прием контрастного душа, употребление здоровой пищи, богатой полезными веществами, а также витаминных комплексов позволяют в короткие сроки восстановить защитную функцию организма и увеличить скорость обмена веществ.
Народные средства против ячменя на глазу
Для увеличения эффективности лечения ячменя можно использовать некоторые народные методы. В случае если фурункул уже начал формироваться и остановить этот процесс с помощью лекарственных средств не представляется возможным, можно поспособствовать его быстрому созреванию. Для ускорения созревания ячменя и его прорыва лучше всего использовать теплые компрессы. В качестве грелки для века глаза идеально подойдет свежесваренное яйцо, завернутое в носовой платок. Завернутое в платок яйцо нужно прикладывать на несколько секунд к поврежденному веку, а затем убирать, чтобы ткани глаза не перегрелись. Процедуры нужно повторять до тех пор, пока яйцо не остынет. Лучше всего делать прогревание не менее 3 раз в день. Стоит заметить, что в случае частых ячменей подобную процедуру нужно проводить после прихода домой с прогулки на свежем воздухе, так как воздействие тепла улучшит кровоснабжение и местный иммунитет.
Кроме того, для согрева места образования воспалительного процесса можно использовать вату, пропитанную теплым чаем или ромашковым отваром. Такие компрессы не только позволят быстрее избавиться от ячменя, но и снять воспаление. Согревать ячмень можно только на самом раннем этапе появления фурункула. После появления видимого стержня гнойника греть его не стоит, так как это может привести к увеличению полости абсцесса и рецидиву фурункула.
Лечить ячмень можно и с помощью сока алоэ. Это растение известно своими противомикробными и противовоспалительными свойствами, поэтому средства на его основе являются едва ли не самыми эффективными в борьбе с ячменем. Лучше всего для устранения ячменя использовать примочки на основе сока алоэ. Сок следует выдавить из свежего зеленого листа и разбавить теплой, кипяченой водой из соотношения 1:10. Подобные примочки нужно использовать не менее 3-х раз в день.
Помимо всего прочего, для лечения ячменя можно использовать свежие листья подорожника. Их нужно тщательно промыть холодной водой. Прикладывать очищенный лист нужно каждые 2-3 часа примерно на 5 минут. Народные средства против ячменя могут использовать только в качестве вспомогательных, после согласования с лечащим врачом.
Меры профилактики против ячменя
Главными мерами профилактики появления ячменя можно считать средства, направленные на устранение главных предрасполагающих факторов. Всем людям, имеющим слабый иммунитет, с наступлением холодов обязательно нужно начинать прием витаминных комплексов и других препаратов, способных поднять иммунитет. Кроме того, нужно одеваться соответственно погоде, ведь чаще появление ячменя наблюдается у людей, которые часто переохлаждаются.
В случае если человек, помимо частых ячменей, имеет и постоянные простуды, необходимо обратиться к иммунологу для выявления расстройства и его лечения. Частые прогулки на свежем воздухе, контрастный душ, занятия спортом, правильное питание способствуют укреплению иммунной системы и устранению первопричины появления ячменя.
Помимо всего прочего, очень важно тщательно следить за гигиеной глаз, особенно это касается женщин. Все кисточки и другие средства для нанесения косметики на области глаз нужно время от времени подвергать дезинфекции, а перед наложением макияжа обязательно мыть руки с мылом. Для поддержания гигиены глаз нужно промывать веки отваром ромашки или зверобоя.
Механизм развития патологии
Прежде чем понять, от чего появляется ячмень, необходимо выяснить сущность явления. Ячменем называют острое воспаление ресничных волосяных мешочков или сальных желез возле них. Очень часто ячмень сопровождается гнойным процессом.
В зависимости от места, где выходит ячмень, различают такие его виды:
- Внешний. Такой нарыв на глазу вскакивает на внешнем веке (по линии роста ресниц или в области сальных желез возле них).
- Внутренний. Такое заболевание еще называют мейбомит, поскольку происходит воспаление мейбомиевых желез. При этом образование вскрывается в конъюнктивальный мешок.
Локализуются ячмени на обоих глазах. То есть страдает как правый, так и левый глаз. Чаще возникает нарыв на верхнем веке. Если вскочил ячмень, то главная причина его появления – это бактериальная инфекция, которая чаще всего связана со стафилококками или стрептококками. Проникая внутрь организма, эти патогенные микроорганизмы могут провоцировать множество заболеваний.
Как же развивается вскочивший нарост на глазу? В первую очередь, происходит заражение бактериальной инфекцией. Также возможна активизация уже имеющейся в организме инфекции вследствие некоторых факторов (понижение иммунитета).
После заражения развитие патогенного процесса происходит в несколько этапов:
- На первом этапе появляется опухание века, покраснение конъюнктивы глаза. Характерный признак ячменя – возникает сильная боль в области его локализации.
- На пике заболевания наблюдается образование головки желтого цвета. Это место скопления гноя.
- После вскрытия ячменя должно выйти много гноя. Дальше происходит заживление раны.
- После того как из нарыва вышло все содержимое, наблюдается быстрое выздоровление. На месте ячменя обычно не остается шрамов или каких-либо следов.
Кроме специфичных признаков существуют также другие симптомы возникновения ячменя на глазу. Среди них:
- резкое повышение температуры;
- может появиться головная боль;
- слезливость глаз;
- сильный зуд, жжение или боль в области нарыва;
- бывает также увеличение близлежащих лимфатических узлов.
Ячмень может появляться не один, часто возникают 2 и более нарывов на веке. Тогда заболевание протекает более болезненно и длительно, а названные выше симптомы проявляются сильнее.
Что делать, если выскакивает ячмень на глазу? Новообразование, особенно в период его набухания, не рекомендовано греть. Также противопоказано выдавливать из него гной. Это может спровоцировать негативные последствия, инфекция распространиться по глазу. В результате могут возникать такие последствия:
- флегмона глазницы;
- тромбоз пещеристого синуса мозга;
- менингит;
- сепсис (распространение инфекции по телу).
Основные причины заболевания
Многие люди при появляющихся нарывах на веках начинают паниковать, поскольку опасаются за свое здоровье (в первую очередь – зрение). Чтобы понять, опасен ли такой нарыв, нужно выяснить, какие основные причины появления ячменя на глазу. Итак, как уже было сказано выше, когда выскочил ячмень на глазу, то главная причина его появления – это бактериальная инфекция, которая попадает внутрь организма.
Чаще всего ячмени провоцируют такие виды патогенных бактерий:
- стафилококк (особенно золотистый стафилококк около 90% случаев);
- стрептококк;
- синегнойная палочка;
- кишечные инфекции.
Также заболевание может возникнуть вследствие глистной инвазии. Заражение гельминтами нечасто приводит к появлению нарывов на веках, однако такие случаи известны.
Факторы риска
Любая инфекция может находиться в организме достаточно долгое время, никак себя не проявляя. Но существует ряд факторов, которые приводят к активизации патогенных микроорганизмов, их размножению и вредоносному действию на человека. Среди таких факторов выделяют:
-
Снижение иммунитета. Когда организм человека истощен, он не способен бороться с инфекцией, которая его атакует. Иммунитет ослабевает по разным причинам. Среди них:
- длительное переохлаждение;
- физические или психические перегрузки;
- длительные тяжелые болезни;
- инфекционные заболевания;
- послеоперационный период;
- проблемы с кровью (анемия);
- простудные болезни;
- частые стрессы;
- болезни, направленные на уничтожение иммунной системы (ВИЧ, СПИД).
- Несоблюдение элементарных правил гигиены. В первую очередь, это касается детей. Они могут немытыми руками тереть глаза, вследствие чего попадает инфекция и развивается воспалительный процесс. А вот у взрослого человека другая проблема – использование чужих предметов гигиены (полотенец, мочалок), косметических средств (тушь, тени и другие), через которые возможно заражение.
-
Внешние факторы. Среди них:
- раздражение слизистой глаз пылью, которая находится в воздухе;
- попадание в глаза мельчайших инородных тел;
- попадание в глаза различных аллергенов;
- раздражение глаз некачественными косметическими средствами.
- Болезни глаз. Это конъюнктивит (воспаление глазной слизистой оболочки) или блефарит (воспаление края века).
- Наследственная предрасположенность.
- Нарушение обмена веществ.
- Недостаток витаминов (гиповитаминоз). Часто такое состояние связано с плохим питанием.
- Наличие клеща, который обитает на ресницах. Его называют демодекс.
Роль иммунитета
Если ячмень появляется постоянно (2-3 раза в год), то, скорей всего, человек имеет слабый иммунитет, который не способен бороться с бактериальной инфекцией. В таком случае врачи рекомендуют разными способами укреплять свою иммунную систему. Ячмень не вылезет, если придерживаться таких действий:
- принимать иммуностимуляторы, способствующие повышению защитных свойств организма (Иммунал);
- периодически принимать комплексы витаминов (Супрадин);
- укреплять организм с помощью физической активности, закаливания;
- правильно и полноценно питаться;
- вовремя лечить простудные и инфекционные болезни.
Прежде чем браться за лечение ячменя, нужно выявить причину его образования. Чаще всего поражение век в виде нарывов провоцирует стафилококковая инфекция, которая активизируется при снижении иммунитета человека.
Психосоматика и появление ячменя
Иногда появившийся ячмень на глазу не имеет объективной причины. Вроде, иммунитет у человека хороший, питание полноценное, он ведет здоровый образ жизни, не нервничает, не имеет болезней, а нарыв над глазом появляется. Что еще может провоцировать ячмень? Ответ на этот вопрос дает психосоматика – направление в медицине и психологии. Она изучает влияние психологических факторов на появление и течение телесных (соматических) болезней.
Выделяют такие психосоматические причины возникновения ячменя:
- Агрессия. Это главная причина появления ячменей. Сюда же можно отнести раздражительность, негативные эмоции. Такие состояния истощают организм, приводят к ослаблению иммунитета. Как следствие – появление гнойников на глазах. Злой человек – эмоционально слабый, также он теряет много жизненной энергии.
- Гнев. Его накопление приводит к эмоциональному истощению, что влияет на здоровье человека, уменьшая его жизненный потенциал.
- Страх. Страх подрывает жизненные силы человека. Постоянный страх нового, страх потерять работу или любимого негативно влияет на здоровье. Человек перестает получать положительные эмоции, его действия становятся автоматическими, из жизни уходит радость. Вследствие этого вероятность появления нарыва на глазах в разы увеличивается.
- Излишняя эмоциональность. Сверхчувствительные люди склонны к возникновению воспалительных процессов, поскольку они подвержены постоянному психологическому напряжению.
Многие специалисты изучали эти причины появления ячменя. Даже опытный офтальмолог, прежде чем поставить диагноз, проводит беседу с пациентом. Это нужно для выяснения возможных психологических факторов возникновения воспалительного процесса на глазу.
Главная причина появления ячменей – патогенное действие бактериальной инфекции. Она активизируется при ослаблении иммунитета человека. Однако это не единственная причина – многие специалисты считают, что не меньшее значение в развитии патологии имеют психосоматические нарушения. В связи с этим самостоятельно выявить и устранить причину заболевания бывает крайне проблематично, поэтому при обнаружении ячменя стоит обратиться к специалисту.